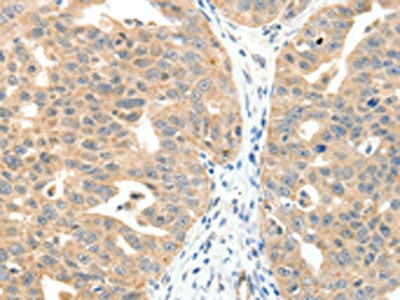

MAP3K14 Antibody
-
中文名稱:MAP3K14兔多克隆抗體
-
貨號:CSB-PA206897
-
規格:¥1100
-
圖片:
-
The image on the left is immunohistochemistry of paraffin-embedded Human ovarian cancer tissue using CSB-PA206897(MAP3K14 Antibody) at dilution 1/20, on the right is treated with fusion protein. (Original magnification: ×200)
-
The image on the left is immunohistochemistry of paraffin-embedded Human lung cancer tissue using CSB-PA206897(MAP3K14 Antibody) at dilution 1/20, on the right is treated with fusion protein. (Original magnification: ×200)
-
Gel: 8%SDS-PAGE, Lysate: 40 μg, Lane: Mouse lung tissue, Primary antibody: CSB-PA206897(MAP3K14 Antibody) at dilution 1/200, Secondary antibody: Goat anti rabbit IgG at 1/8000 dilution, Exposure time: 10 minutes
-
-
其他:
產品詳情
-
Uniprot No.:
-
基因名:
-
別名:MAP3K14 antibody; FTDCR1B antibody; HS antibody; HsNIK antibody; M3K14_HUMAN antibody; Map3k14 antibody; Mitogen activated protein kinase kinase kinase 14 antibody; Mitogen-activated protein kinase kinase kinase 14 antibody; NF kappa beta inducing kinase antibody; NF-kappa-beta-inducing kinase antibody; NIK antibody; Serine/threonine-protein kinase NIK antibody
-
宿主:Rabbit
-
反應種屬:Human,Mouse
-
免疫原:Fusion protein of Human MAP3K14
-
免疫原種屬:Homo sapiens (Human)
-
標記方式:Non-conjugated
-
抗體亞型:IgG
-
純化方式:Antigen affinity purification
-
濃度:It differs from different batches. Please contact us to confirm it.
-
保存緩沖液:-20°C, pH7.4 PBS, 0.05% NaN3, 40% Glycerol
-
產品提供形式:Liquid
-
應用范圍:ELISA,WB,IHC
-
推薦稀釋比:
Application Recommended Dilution ELISA 1:1000-1:5000 WB 1:200-1:1000 IHC 1:25-1:100 -
Protocols:
-
儲存條件:Upon receipt, store at -20°C or -80°C. Avoid repeated freeze.
-
貨期:Basically, we can dispatch the products out in 1-3 working days after receiving your orders. Delivery time maybe differs from different purchasing way or location, please kindly consult your local distributors for specific delivery time.
-
用途:For Research Use Only. Not for use in diagnostic or therapeutic procedures.
相關產品
靶點詳情
-
功能:Lymphotoxin beta-activated kinase which seems to be exclusively involved in the activation of NF-kappa-B and its transcriptional activity. Promotes proteolytic processing of NFKB2/P100, which leads to activation of NF-kappa-B via the non-canonical pathway. Could act in a receptor-selective manner.
-
基因功能參考文獻:
- A TRAF3-NIK axis differentially regulates viral DNA vs RNA pathways in innate immune signaling. PMID: 30018345
- Data show that breast cancer stem cells (BCSCs) expressed higher levels of NF-kappaB-inducing kinase (NIK). PMID: 27876836
- These findings highlight the importance of NIK in tumor pathogenesis and invite new therapeutic strategies that attenuate mitochondrial dysfunction through inhibition of NIK and Drp1. PMID: 27889261
- results suggest that changes in the relative concentrations of RelB, NIK:IKK1, and p100 during noncanonical signaling modulate this transitional complex and are critical for maintaining the fine balance between the processing and protection of p100. PMID: 27678221
- report a detailed state-of-the-art mass spectrometry-based protein-protein interaction network including the noncanonical NF-kappaB signaling nodes TRAF2, TRAF3, IKKalpha, NIK, and NF-kappaB2/p100; also provide a differential interactome of NIK mutants that cause immunodeficiency PMID: 27416764
- OLFM1 is a negative regulator of non-canonical NF-kappaB signalling by interacting with and inhibiting NIK. Thus, OLFM1 may serve as a valuable biomarker and therapeutic target for colorectal cancer (CRC) patients. PMID: 27555280
- The expression of OTUD7B and NIK were negatively correlated in non-small cell lung cancer tumor samples. the higher expression of NIK was related to more lymph node metastasis and later TNM stage. high OTUD7B/low NIK index can predict an good prognosis. PMID: 27499151
- NIK expression was significantly increased in the tumor tissue of patients with breast carcinoma, which may be an important factor that affects the prognosis of these patients. PMID: 26823811
- This study identified two novel independent loci (MAP3K14 and CARD9) strongly associated with joint damage in Mexican Americans and European Americans and a few shared loci showing suggestive evidence for association. PMID: 26498133
- The forced expression of NDRG2 in ATL cells down-regulates not only the canonical pathway by inhibiting AKT signaling but also the non-canonical pathway by inducing NF-kappaB-inducing kinase (NIK) dephosphorylation via the recruitment of PP2A PMID: 26269411
- NIK(+) endothelial cells may play an important role in the persistence of synovitis PMID: 26178280
- Data suggest microRNA302c, but not microRNA520e, promotes replication of influenza A virus H3N2 although the two microRNAs target same site of NFkappaB-inducing kinase (MAP3K14) 3prime untranslated region; studies were conducted in lung epithelial cells. PMID: 26602079
- by demonstrating a critical role of NIK in mediating NF-kappaB activation and BAG3 induction upon ST80/Bortezomib cotreatment, our study provides novel insights into mechanisms of resistance to proteotoxic stress in RMS PMID: 25766331
- Loss-of-function mutations in NIK can cause B-cell lymphopenia, hypogammaglobulinemia, impaired ICOSL expression, and disordered T helper cell and NK cell function. PMID: 25406581
- Membrane attack complexes activate noncanonical NF-kappaB by forming a novel Akt(+)NIK(+) signalosome on Rab5(+) endosomes. PMID: 26195760
- Authors show that activation of NF-kappaB by Kaposi's sarcoma-associated herpesvirus K15 protein involves the recruitment of NF-kappaB-inducing kinase (NIK) and IKK alpha/beta to result in the phosphorylation of p65/RelA on Ser536. PMID: 25187543
- NIK plays a key role in constitutive NF-kappaB activation and the progression of ovarian cancer cells PMID: 24533079
- Identification and function of the NIK IAP binding motif, which promotes c-IAP1-dependent ubiquitylation of NIK. PMID: 25246529
- These studies provide evidence for a role of NF-kappaB-inducing kinase (NIK) and subsequent non-canonical NF-kappaB signalling in pathological angiogenesis PMID: 25043127
- Results show that nuclear factor-kappa B inducing kinase has a role in graft-versus-host disease by maintaining the viability of activated alloreactive T lymphocytes. PMID: 20823135
- NIK is a new therapeutic target for Mantle cell lymphoma treatment, particularly for lymphomas that are refractory to B cell receptor pathway inhibitors. PMID: 24362935
- A pivotal role for NIK in nuclear factor kappa B activation and regulation of gene expression in T-cell lymphoma. PMID: 23536439
- TRAF2/NIK/NF-kappaB2 pathway regulates pancreatic ductal adenocarcinoma cell tumorigenicity PMID: 23301098
- APPL1 regulates basal NF-kappaB activity by modulating the stability of NIK, which affects the activation of p65. PMID: 22685329
- we found that NIK and the noncanonical pathway are very prevalent in Hodgkin lymphoma PMID: 22968463
- study shows API2-MALT1 fusion oncoprotein induces proteolytic cleavage of NF-kappaB-inducing kinase (NIK); resulting deregulated NIK activity is associated with constitutive noncanonical NF-kappaB signaling, enhanced B cell adhesion and apoptosis resistance PMID: 21273489
- a molecular basis for the recent observation of gain-of-function activity for an N-terminal deletion mutant (DeltaN324) of NIK, leading to constitutive non-canonical NF-kappaB signaling with enhanced B-cell adhesion and apoptosis resistance. PMID: 22718757
- NIK is one of the direct target genes of miR-520e. PMID: 22105365
- NIK mediates both beta-catenin and NF-kappaB regulated transcription to modulate melanoma survival and growth PMID: 21963849
- Genetic lesions of the TRAF3 and MAP3K14 genes in classical Hodgkin lymphoma. PMID: 22469134
- NIK activity in nonhematopoietic cells controls Th2 cell development and prevents eosinophil-driven inflammatory disease, most likely using a signaling pathway that operates independent of the known NIK substrate IKKalpha. PMID: 22474019
- Cigarette smoke and TNFalpha increase NIK levels causing phosphorylation of IKKalpha, which leads to histone acetylation. PMID: 21887257
- A role for NF-kappaB noncanonical pathway activation in modulating diabetes-induced inflammation in renal tubular epithelium. PMID: 21869881
- Adiponectin treatment inhibited NIK-induced NF-kappaB activation and restored insulin sensitivity by restoring phosphatidylinositol 3 kinase activation and subsequent serine-threonine kinase phosphorylation. PMID: 21846802
- findings suggest that the CC genotype of NIK rs7222094 is associated with increased mortality and organ dysfunction in septic shock patients, perhaps due to altered regulation of NF-kappaB pathway genes, including CXCL10 PMID: 21257964
- plays a key role in constitutive NF-kappaB activation in non-small cell lung cancer cells PMID: 20338663
- TNF-alpha and carrageenan in combination act to increase NIK phosphorylation, thereby increasing activation of the non-canonical pathway of NF-kappaB activation PMID: 20937806
- Data suggest that NIK and genes induced by the NIK-mediated constitutive NF-kappaB activation could be therapeutic targets of basal-like breast cancer. PMID: 20735436
- An atypical E3 ligase zinc finger protein 91 stabilizes and activates NF-kappaB-inducing kinase via Lys63-linked ubiquitination. PMID: 20682767
- Data show that NIK with mutations in the IKKalpha-targeted serine residues was more stable than wild-type NIK and resulted in increased noncanonical NF-kappaB signaling. PMID: 20501937
- These results suggest that augmentation of NF-kappaB-inducing kinase, IkappaB kinase-alpha, and pH3 in response to oxidative stress is involved in cell death after cerebral ischemia (or stroke). PMID: 20125184
- the LTbetaR modifies the ubiquitin:NIK E3 ligase, and also acts as an allosteric regulator of the ubiquitin:TRAF E3 ligase PMID: 20348096
- Data provide analysis of the IKK/NIK inter-relationship and its impact on NF-kappaB control by mathematical modelling. PMID: 19909783
- results demonstrate that IKK2 is essential for dendritic cell activation induced by CD40L or contact with allogeneic T cells, but not by LPS, whereas NIK is not required for any of these signals PMID: 12393548
- induction of noncanonical NF-kappaB signaling may involve the rescue of NIK from TRAF3-mediated negative regulation PMID: 15084608
- subcellular distribution of NIK to different compartments might be a means of regulating the function of this kinase PMID: 15252129
- Results for the first time place NF-kappa B-inducing kinase (NIK), previously shown to function in TNF signaling, within the interferon signal transduction pathway PMID: 16009713
- This study demonstrates that NF-kappaB-inducing kinase (NIK) is a critical target of the endogenous ROS in NF-kappaB pathways. PMID: 17729113
- NF-kappaB-inducing kinase phosphorylates and blocks the degradation of Down syndrome candidate region 1 PMID: 18056702
- NIK functions downstream of Cot to mediate p65 phosphorylation. PMID: 18439422
顯示更多
收起更多
-
亞細胞定位:Cytoplasm.
-
蛋白家族:Protein kinase superfamily, STE Ser/Thr protein kinase family, MAP kinase kinase kinase subfamily
-
組織特異性:Weakly expressed in testis, small intestine, spleen, thymus, peripheral blood leukocytes, prostate, ovary and colon.
-
數據庫鏈接:
Most popular with customers
-
-
YWHAB Recombinant Monoclonal Antibody
Applications: ELISA, WB, IHC, IF, FC
Species Reactivity: Human, Mouse, Rat
-
Phospho-YAP1 (S127) Recombinant Monoclonal Antibody
Applications: ELISA, WB, IHC
Species Reactivity: Human
-
-
-
-
-